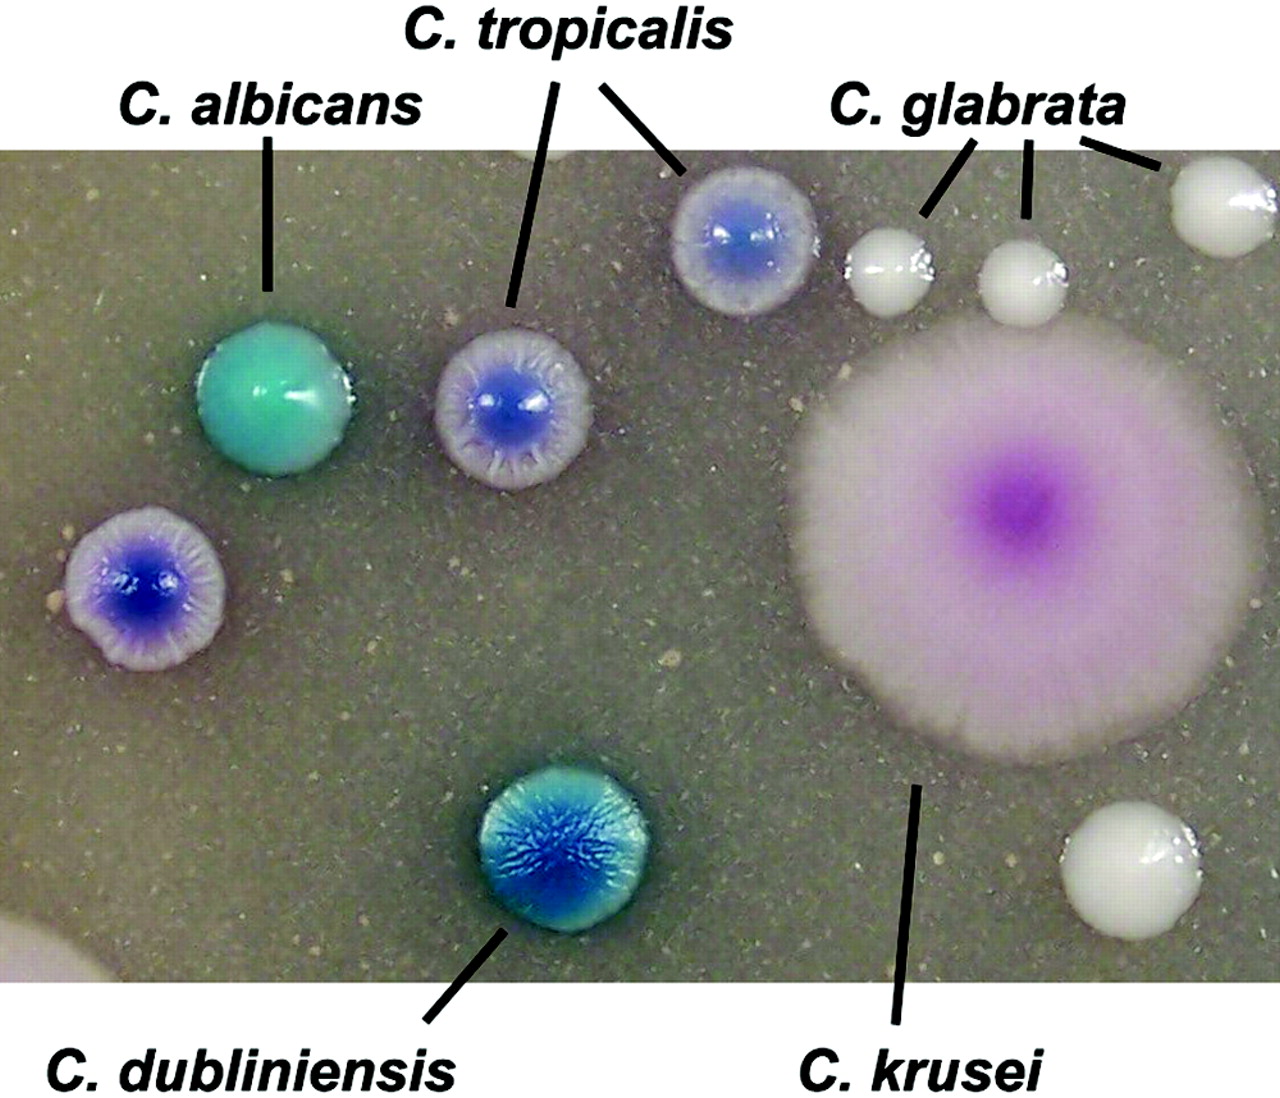

Tropicali 1.0
Глент страшные гугл карты
Карты действий для детей
Частный визит в миграционной карте
Большие купюры денег во сне
Достоевского 58 новосибирск
Ислама махачева против дастина порье
Куньлунь где арена
Веселый грустный это антонимы
Резина на 14 165 70
21.08 1996
Богослужебные указания на 5 сентября 2025
Manhattan fm
Расшифровка основания платежа в налоговую 106
Tropicali 1.0 116 фотографий